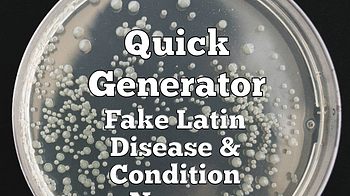

Book Devlogs Page 17
If you've preordered Killer Debt here on Itch, you should be able to download it now! And if you've been waiting for it to come out, well, now it has! Go grab y...
1 file
If you've preordered Killer Debt here on Itch, you should be able to download it now! And if you've been waiting for it to come out, well, now it has! Go grab y...
1 file
SI SOLDADOS! EL PRIMER LIBRO DE REDMAX en este caso una pieza pequeña e incompleta del lore de redmax para la gente que recien va entrando a este mundo corromp...
1 file
A Gordian cycle story goes through the following stages: - The first draft is written in a physical notebook, with editing notes randomly strewn in the margins...
In my quest to make my games more accessible, I'm adding plain text files versions (.txt) both in English and Portuguese...
2 files
Just saying that the version here has been updated after being able to go in and make revisions and additions for clarity...
2 files
Jerome Savidan / PortfolioGrafx · GitLab...
1 file
Un fanzine francophone sur l'Atari Portfolio
Planning to add the following Japanese and oriental books: The Tale of Genji 源氏物語 Murasaki Shikibu 11th century First novel in world literature, depicti...
EXCLUSIVE Itchio Scif Book Sale. The World In My Hands, a creepy scifi mystery aboard an alien-built colony ship for just 99c until 5th May...
1 file
We've uploaded a second version of Issue 1, with single-page layout. This may be easier to read on phones. Content is the same, of course...
1 file
Mainly notes for myself. Will redo the ending (so that one can try over and over again). This is meant to be a philosophical short...
1 file
If you want a signed paperback copy of Dionysus in Wisconsin, I have sixty beautiful new copies burning a hole in my pocket...
The World In My Hands lands on Itch.io Newly available, The World In My Hands is a scifi meets clifi ebook that holds a Literary Titan Gold Award. Join Seth and...
1 file
Hello everyone! Thank you so much for your support of my first zine, this meant the world to me! I have added printable versions in two sizes, so that you can e...
2 files
Available sections: Playable catalog , Search by title , Search by author, Japanese and oriental books . Can't find your favorite title? Request your favorite b...
1 file
In honor of Lesbian Visibility Week, Cat/Mouse is on sale through April 27th, 2025! While I do not identify as a lesbian myself, I am a queer woman who loves an...
When I first started Spiritfarer , I didn’t expect to cry. I didn’t expect to feel so attached. Or to say goodbye so many times. But as I played, as each sp...
The Barrie Children's Hospital is holding its annual fundraising gala, and as usual all of Britain's brightest luminaries are invited. This year, however, there...
Hey! I'm impatient and itch.io has always been good for me, so I've uploaded the files! If you've pre-ordered it, you should be able to download it now (if not...
2 files
Chapters 3 and 4 have been added. Polished some dialog...
3 files
Shylock [ shahy-lok ]: noun: a person who lends money, often with the intention of exploiting their borrowers.
"Kaleidoscopic Absolution - Silver Fanzine" pdf has been updated to include "spreads" and "pages" versions of the zine. The main file has therefore been updated...
1 file
Minor adjustment on cover page...
1 file
Stick it to the system. One ride at a time.
Boa noite pessoal, estou vendo que muitas pessoas estão interessadas em jogar o sistema, e vejo que muitas pessoas estão tentando pedir acesso ao modelo da fi...
I'm releasing all of my Old Chrome series, featuring renegade marshal Miles Kim. Book one is The Seraph Engine. It's sold in over thirty-five countries and hit...
1 file
I have added a second file which has "for printing" in the name because I finally made my first copies! If you want your own personal copy, to share it with oth...
1 file
Hi everyone! You can now get The Little Book of Lesser Known Monsters on audiobook right here on itch.io! This project was narrated by Joel Froomkin. Hope you e...
3 files
Fixed 3 typos. Included an epub version for e-reader users. If you need any other formats please let me know in the comments...
Since the last development log, I've been continuing to review and add more of other people's projects to this directory to feature them and bring people's atte...
I added and updated a lot of dialog. Chapters 1 and 2 are done...
3 files
Siamo entrati ufficialmente nella fase di produzione artistica di Mater Tenebra . Dopo mesi di scrittura e test, abbiamo iniziato a realizzare le prime illustra...
1 file
I've nearly finished the first draft of Spearhand Faring . That doesn't mean that the poem's done: plenty of editing remains. But it's a big step forward. This...
1. Writing: The stories are, as my framing device hopefully communicates, meant to have been passed down orally for a long time, until with the (re)introduction...
It's out! Dreaming Spires is my weird, psychogeographic sort-of-true story that I wrote way back in 2021. My design skills weren't as good then as they are now...
2 files
chapter 1 - 4 is out. Download it and read it and please leave some review or comment. I am not a writer. This is the story of a dream i once had and it’s bee...
4 files
This is part of an on going story that I started nearly 10 years ago. The title is in its infancy. There are currently no pictures or music...
2 files
Book is nearly ready so you know what time it is!!!! pre order Pax-56 today!...
1 file
She didn’t pose. She didn’t perform. She just stayed in the light long enough for it to undo her. The Frame was written as six stills—each one closer, slo...
2 files
This isn’t about exposure. Not really. He doesn’t undress. He doesn’t speak. He doesn’t ask for anything. He pumps. He dresses. He shows up. And when th...
2 files
She said it first. Not him. Not the moment. Not the shame. Her. "Wreck me better." This book wasn’t built on command. It wasn’t built on language games or r...
2 files
Synthetic Sea got a shoutout in the queer books weekly blog this week! Find the post here <3...
The Trial (Der Process) by Franz Kafka Siddhartha by Hermann Hesse The Idiot (Идиот) by Fyodor Dostoevsky Tarzan of the Apes by Edgar Rice Burroughs The Ca...
You can now--right now!--read the seventh entry in the Gordian cycle, The Combat of Morgan and Kaya ! Which if I was more stylistically adventurous would be cal...
2 files
Well, it's November 17th, it was around this time last year that- Well, it's the end of the year time to- Well, it’s been over an year since I set out to make...
Currently out of Dionysus in Wisconsin paperbacks. Old Time Religion and Troth are still in stock, as are all the ebooks (of course)...
1 file
Cat/Mouse is an 18,000-word novella about a human bounty hunter and the alien art thief she's contracted to catch. Set on a futuristic space station and full of...
Another one thats been on the To-Do list for ages, fake latin sounding names for diseases and conditions. Technically, the full title should be "Quick Generator...
Go here to grab it!...
A fortnightly retro gaming and media fanzine
Loading more posts...